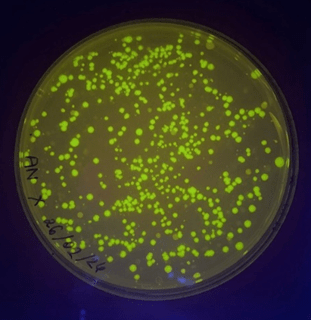
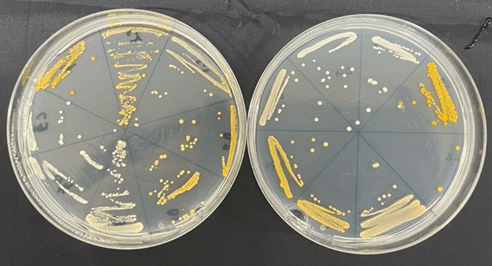

Introduction
Experiment 1 – CRISPR Gene Editing of BFP to GFP in the Yeast Genome
- Used CRISPR/Cas9 technology to edit the yeast genome to convert the blue fluorescent protein (BFP) gene to green fluorescent protein (GFP)
- Designed guide RNAs (gRNAs) to target the BFP gene, introducing double-strand breaks and supplying a donor DNA template containing the GFP sequence for homology-directed repair
- Allowed the integration of the GFP gene at the location of the BFP gene
- Monitored fluorescence to confirm the successful gene edit.
From this experiment, I gained a deep understanding of genome editing techniques, particularly the precision and efficiency of the CRISPR/Cas9 system. This experience developed my skills in genetic engineering and molecular biology techniques.
Experiment 2 – Golden Gate Assembly of Defined and Combinatorial Metabolic Pathways
- Applied the Golden Gate Assembly method to construct defined and combinatorial metabolic pathways in yeast.
- Assembled multiple DNA fragments in a specific order, creating genetic circuits to test metabolic pathway variations
- Determined how different pathway combinations affect the production of a target compound, assessing the functionality of assembled pathways by analysing product yields
I learned how to efficiently design modular DNA components and assemble them in a single step. This experiment honed my skills in metabolic engineering and DNA assembly techniques, emphasising the value of modularity and combinatorial approaches in synthetic biology.
Experiment 3 – Promoter Modification of the Carotenoid Biosynthesis Pathway
- Modified promoters in the carotenoid biosynthesis pathway to study their effect on gene expression and carotenoid production
- Aimed to increase gene expression by altering the Kozak sequence by increasing translation efficiency
I gained insight into transcriptional regulation and promoter engineering. I learned how small changes in promoter sequences could have large effects on gene expression.
Find out more from my report!